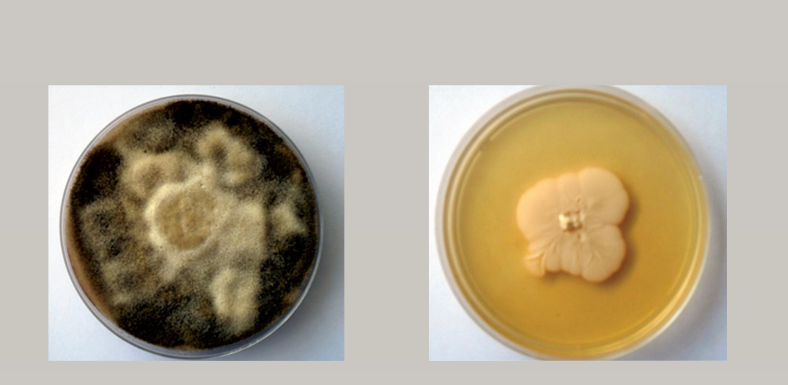
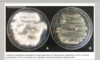

os fungos faz sintese de ?
ergosterol
O que causa criptococosneofornix?
causa minigite fungica
O que causa criptococosneofornix?
causa minigite fungica
Qual liquido usamos para fazer teste de menigites ?
liquido cefaloraquidio
oque se obsrva nos 2 agar caracteristicas macroscópicas ?

Da esquerda
vemos características de fungos filamentosos
sendo elas
Cor mais escura
Aspecto rugoso
Aspecto aveludado
se desenvolve em temperatura de 25º
Da direita
vemos um fungo levedura e forme
temperatura se desenolve a de 32 a 37º
aspecto de cor mais clara
é cremoso, pastoso
Caracteristicas gerais dos fungos ?
gostam de uma PH ácido entre 5.6 a 5.8
Característica de forma microspica dos filamentosos ?
São multicélulares
células alargadas apresenta conideos

Características das células levedurasforme ?
célula unicelular
célular de forma circular e ovalada

Qual o ambiente propício
Para fungo ?
gosta de PH ácido, escuro
ambiente quente e humido
Sindrome dos edificios dos enfermos são fungos ?
disperso em lugares fechados, como exemplo da candida que fica no ar atmosférico ele causa hipersensibilidade do tipo 1 tem como anticorpo envolvido o IGE e a célula principal encontrada no tecido é os mastócitos e os mastocitos estão carregados de granulos de estamina, causa espirro em caso mais leves em casos mais graves anfilaxia
Descreva a técnica do micro cultivo ?
- Insira a vareta de vidro na placa
- -Colocar el portaobjetos sobre la barra de vidrio
- -Corte um quadrado de meio de cultura (superfície = ¼ da
lamínulas). Coloque-o no slide - -Pegar um fragmento de micélio e inocular nos quatro lados do
meio de cultivo - Colocar as laminula no meio de cultura inoculado.
- -Adicionar água destilada estéril à placa.
- -Fechar a placa e selar com parafilme e incubar por 7 dias a 25ºC
Depois do micro cultivo como é a parte de lá observação ?
◦ Observação
* -Coloque uma gota de lactofenol em uma lâmina limpa
* -Flame as pinças
* -Remova a lamínula
* -Coloque a lamínula sobre a lâmina e aguarde alguns
instantes para o lactofenol agir
* -Observar ao microscópio com a objetiva “forte seco” (x40)
* -Localizar estruturas características do fungo (conidióforos,
esporângios)
Como é feito o processo de semeadura ?
nas extremidades da lamina
Que fungo cresceu ?
fungo filamentoso
Qual tinção utilizada ?
azul de algodão é o mesmo lactofenol
Quais o método direto mais utilizado ?
1- Examen directo en fresco - blanqueo con KOH (hidróxido de potasio) después de la tinción: Gram, Giemsa,
2- Histopatológico - La tinción de hematoxilina y eosina (HE), Gomory, PAS
3- Cultivo: Sabouraud Sabouraud + antibióticos Medios específicos: selectivos e indicadores Examen macroscópico y microscópico
4- Ensayos bioquímicos para identificación Auxonograma: ensayo de asimilación de fuentes de carbono y nitrógeno. Zimograma: prueba de fermentación de carbohidratos y otros.
5- Pruebas inmunológicas para identificar el agente
Qual objetiva de analisar fungo ?
40
qual principal hagar que usamos para fungo ?
agar saboraud de dextrose ele é especifico para fungo
Biopsia quais as tincões usadas e definição
Amuestra de tejido
◦ Tinciones Gomori, Grocott, PAS mucho utilizado para diagnostico de micosis subcutáneas y sistémicas.
◦ Biopsia es imprescindible en lobomicose en que el agente no tiene sido cultivado
Qual PH do agar saboral desctrosa e suas concentrações ?
- Tem PH de 5,8
- alta concetração de glicose e pode-se por clorofenicol que é um antibiótico, usado para inibir o crescimento das batérias para não atrapalhar o crescimento
Qual a função do antifungi-grama ?
Ele é o metódo utilizado para identificar a sensibilidade dos fungos a determinadas medicações
Qual a definição clinica desse paciente

manchas hipocromicas claras esbranquiçadas

Qual micro organismo do pano branco ?
malassezia sp, atua diretamente contra os melanócitos
Na clinica paciente com pano branco apresenta ?
desconforto estético